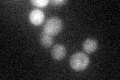
YMR174C
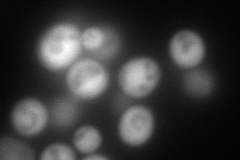
YMR174C
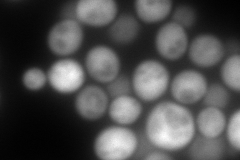
YMR174C
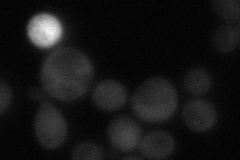
YMR174C
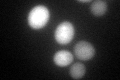
YMR174C

View description
Cytoplasmic proteinase A (Pep4p) inhibitor, dependent on Pbs2p and Hog1p protein kinases for osmotic induction; intrinsically unstructured, N-terminal half becomes ordered in the active site of proteinase A upon contact
Localization:
Intensity:
Fold change:
Significance:
-
C’ GFP library in SD
cytosol33.94 -
N' NOP1pr-GFP in SD
cytosol313.537 -
N' TEF2pr-mCherry in SD
cytosol519.033 -
N' NATIVEpr-GFP in SD
cytosol32.2792 -
N' TEF2pr-VC and Cyto-VN in SD

#N/A0 -
C’ GFP library in SD+DTT
cytosol49.921.47Yes -
C’ GFP library in SD+H2O2

cytosol41.041.2No -
C’ GFP library in Starvation Media

cytosol118.343.48Yes -
C’ GFP library on the background of Pup2-DaMP

N/A -
C’ GFP library on the background of CCT mutant

N/A0N/AYes
